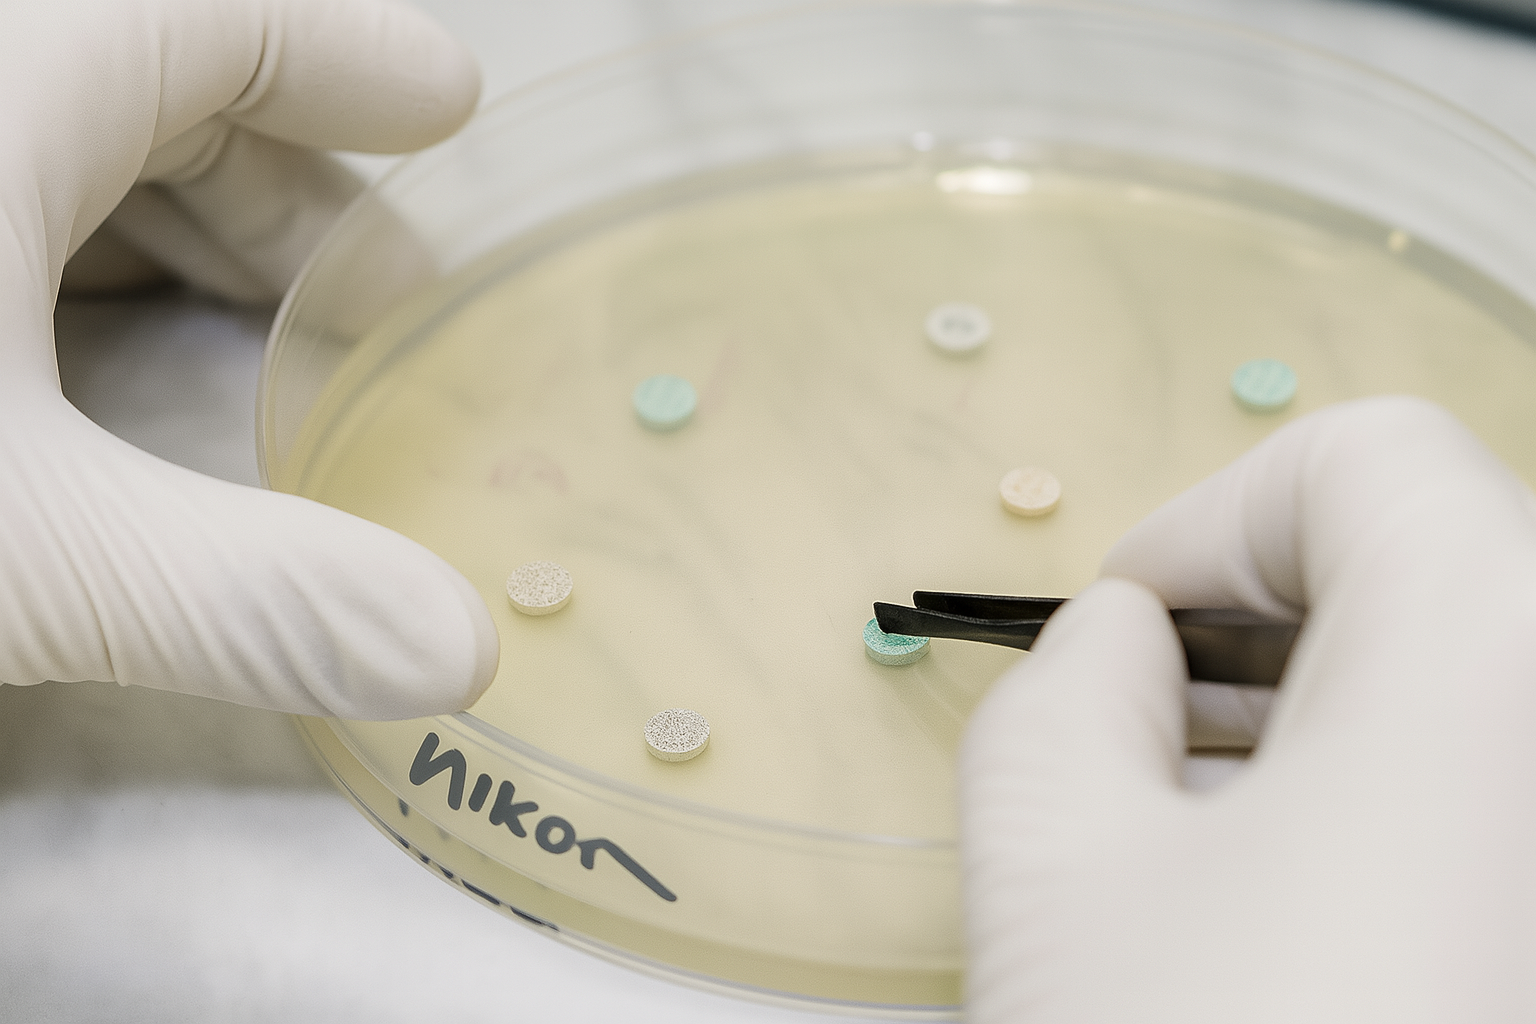

Činnosť oddelenia špeciálnej bakteriológie
Špeciálne bakteriologické vyšetrenia:
- klinický a sekčný materiál na prítomnosť baktérií spôsobujúcich špecifické infekčné ochorenia
- koží a vlny na antrax
- medu, plástov, vosku a meliva na vyšetrenie pôvodcu moru včelieho plodu
- plástov na vyšetrenie hniloby včelieho plodu
- rýb na bakteriálne ochorenia
- komplexné vyšetrenie laboratórnych a ZOO zvierat